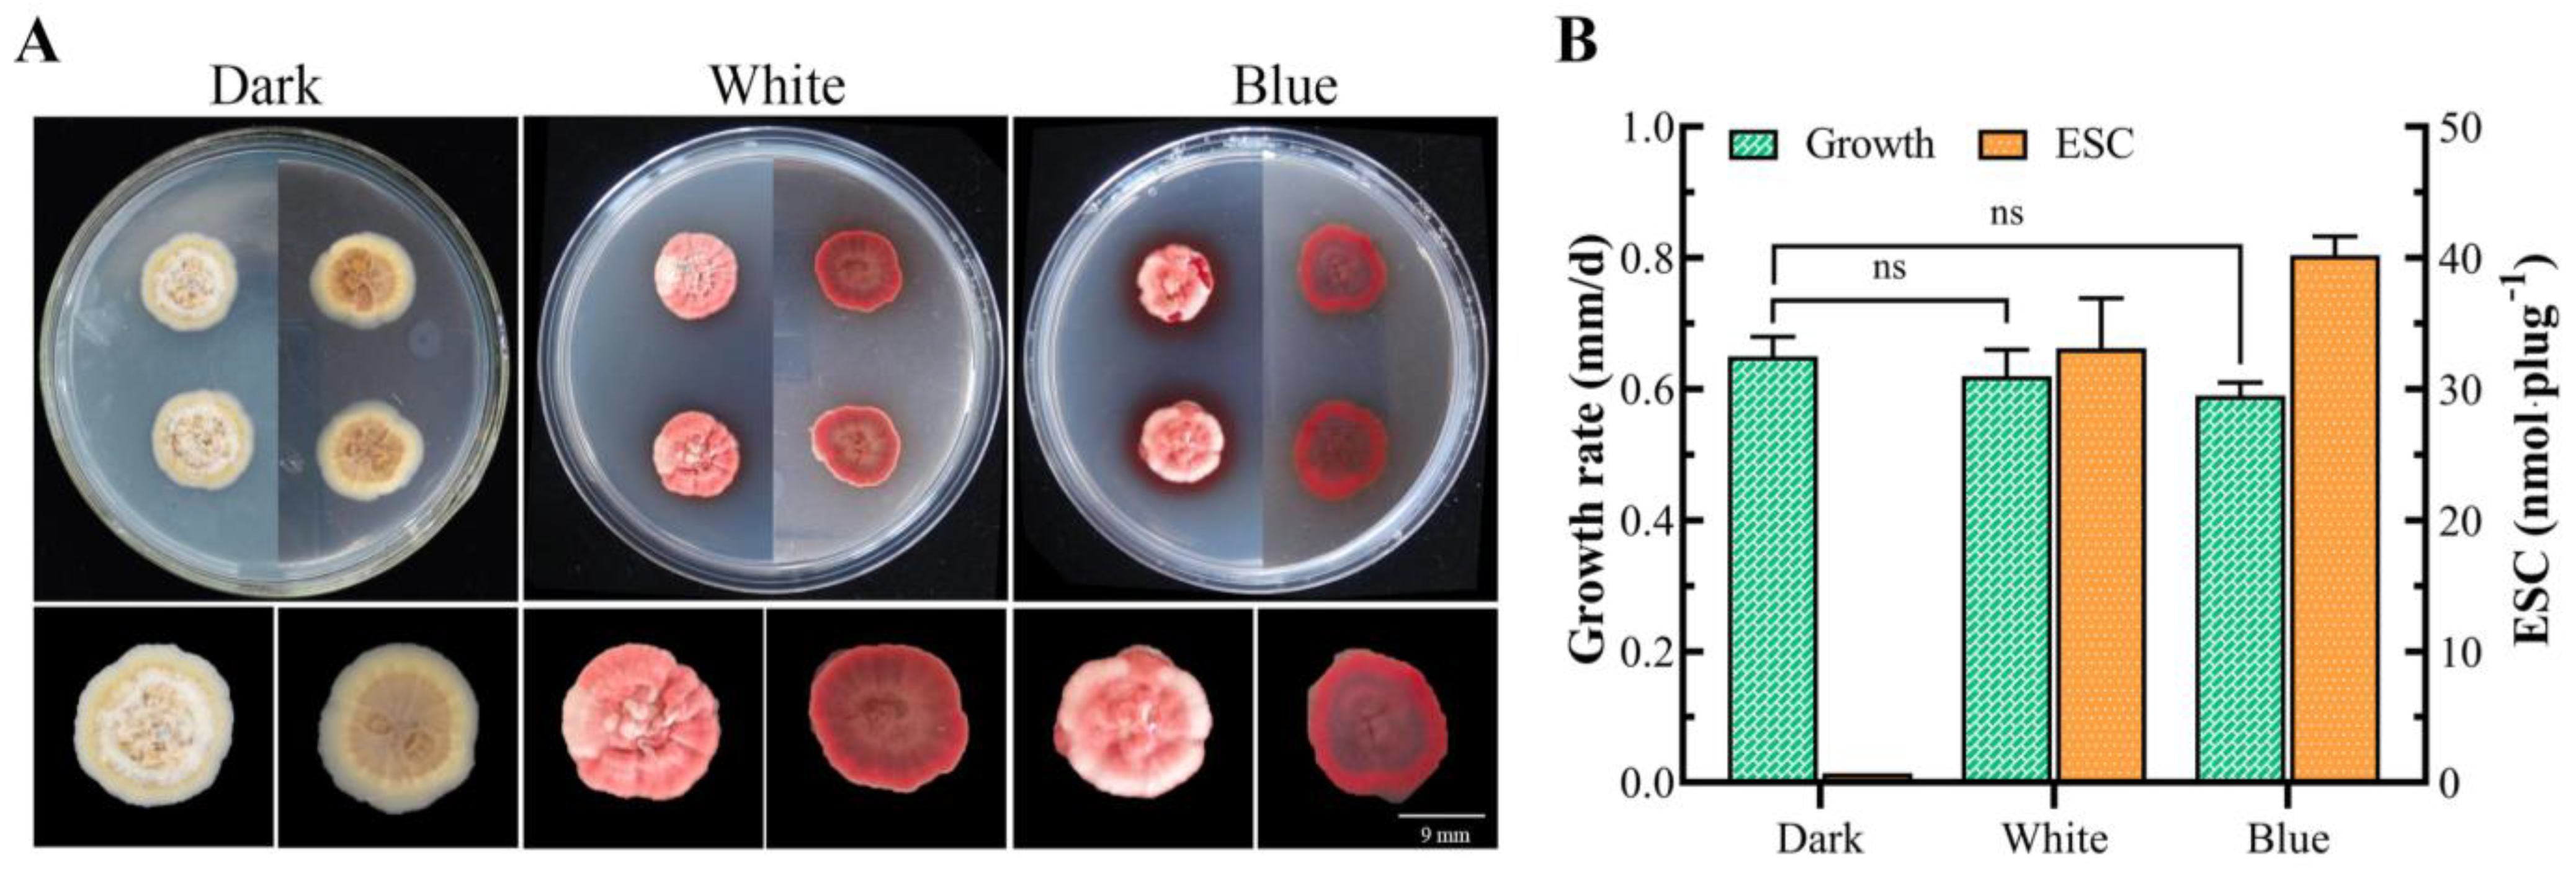
Microorganisms 12 01027 g009

Transcriptome Analysis Reveals Candidate Genes for Light Regulation of Elsinochrome Biosynthesis in Elsinoë arachidis
Abstract
1. Introduction
2. Materials and Methods
2.1. Strain and Culture Conditions
2.2. Extraction of ESC
2.3. RNA Isolation and Sequencing
2.4. Data Analysis
2.5. RT-qPCR Analysis
2.6. Blue White Irradiation
3. Results
3.1. Growth and Toxin Production of E. arachidis
3.2. Summary of the RNA-Seq Data
3.3. Analysis of Differentially Expressed Genes (DEGs)
3.4. GO Classification of Differentially Expressed Genes
3.5. COG Analysis of Differentially Expressed Genes
3.6. KEGG Analysis of Differentially Expressed Genes
3.7. Reveals Candidate Genes for White Light Regulation of Secondary Metabolism
3.8. Genes Related to Biosynthesis of Secondary Metabolites
3.9. RT-qPCR Analysis of Candidate Genes for Light Regulation
3.10. The Effect of Blue Light on Toxin Production
4. Discussion
5. Conclusions
Supplementary Materials
Author Contributions
Funding
Data Availability Statement
Conflicts of Interest
References
- Iwata, K. Fungal toxins as a parasitic factor responsible for the establishment of fungal infections. Mycopathologia 1978, 65, 141–154. [Google Scholar] [CrossRef]
- Möbius, N.; Hertweck, C. Fungal phytotoxins as mediators of virulence. Curr. Opin. Plant Biol. 2009, 12, 390–398. [Google Scholar] [CrossRef]
- Pinto, V.E.F.; Patriarca, A. Alternaria Species and Their Associated Mycotoxins. In Mycotoxigenic Fungi; Methods in Molecular Biology; Humana Press: New York, NY, USA, 2017; pp. 13–32. [Google Scholar] [CrossRef]
- Evidente, A.; Cimmino, A.; Masi, M. Phytotoxins produced by pathogenic fungi of agrarian plants. Phytochem. Rev. 2019, 18, 843–870. [Google Scholar] [CrossRef]
- Bhatnagar, D.; Yu, J.; Ehrlich, K.C. Toxins of Filamentous Fungi. Chem. Immunol. 2022, 81, 167–206. [Google Scholar]
- Xu, D.; Xue, M.; Shen, Z.; Jia, X.; Hou, X.; Lai, D.; Zhou, L. Phytotoxic Secondary Metabolites from Fungi. Toxins 2021, 13, 261. [Google Scholar] [CrossRef]
- Ebert, M.K.; Spanner, R.E.; de Jonge, R.; Smith, D.J.; Holthusen, J.; Secor, G.A.; Thomma, B.P.H.J.; Bolton, M.D. Gene cluster conservation identifies melanin and perylenequinone biosynthesis pathways in multiple plant pathogenic fungi. Environ. Microbiol. 2018, 21, 913–927. [Google Scholar] [CrossRef]
- Geris, R.; Pinho, M.A.; Boffo, E.F.; Simpson, T.J. Naturally Occurring Partially Reduced Perylenequinones from Fungi. J. Nat. Prod. 2022, 85, 2236–2250. [Google Scholar] [CrossRef]
- Gao, J.; Wenderoth, M.; Doppler, M.; Schuhmacher, R.; Marko, D.; Fischera, R. Fungal Melanin Biosynthesis Pathway as Source for Fungal Toxins. mBio 2022, 13, e0021922. [Google Scholar] [CrossRef]
- Daub, M.E.; Herrero, S.; Chung, K.-R. Reactive Oxygen Species in Plant Pathogenesis: The Role of Perylenequinone Photosensitizers. Antioxid. Redox Signal. 2013, 19, 970–989. [Google Scholar] [CrossRef]
- Jiao, W.; Liu, L.; Zhou, R.; Xu, M.; Xiao, D.; Xue, C. Elsinochrome phytotoxin production and pathogenicity of Elsinoë arachidis isolates in China. PLoS ONE 2019, 14, e0218391. [Google Scholar] [CrossRef]
- Chung, K.R. Elsinoë fawcettii and Elsinoë australis: The fungal pathogens causing citrus scab. Mol. Plant Pathol. 2010, 12, 123–135. [Google Scholar] [CrossRef]
- Hu, J.; Sarrami, F.; Li, H.; Zhang, G.; Stubbs, K.A.; Lacey, E.; Stewart, S.G.; Karton, A.; Piggott, A.M.; Chooi, Y.-H. Heterologous biosynthesis of elsinochrome A sheds light on the formation of the photosensitive perylenequinone system. Chem. Sci. 2019, 10, 1457–1465. [Google Scholar] [CrossRef]
- Liao, H.L.; Chung, K.R. Cellular toxicity of elsinochrome phytotoxins produced by the pathogenic fungus, Elsinoë fawcettii causing citrus scab. New Phytol. 2007, 177, 239–250. [Google Scholar] [CrossRef]
- Jiao, W.; Xu, M.; Zhou, R.; Fu, Y.; Li, Z.; Xue, C. Genomic analysis of Elsinoë arachidis reveals its potential pathogenic mechanism and the biosynthesis pathway of elsinochrome toxin. PLoS ONE 2021, 16, e0261487. [Google Scholar] [CrossRef]
- Zhang, X.-T.; Fu, Y.-W.; Jiao, W.-L.; Piao, J.-Z.; Li, Y.; Li, Z.-B.; Zhou, R.-J. Whole genome PKS gene cluster mining and bioinformatics analysis of toxin biosynthesis gene ESCB1 in Elsinoë arachidis. Chin. J. Oil Crop Sci. 2022, 44, 826. [Google Scholar] [CrossRef]
- Love, M.I.; Huber, W.; Anders, S. Moderated estimation of fold change and dispersion for RNA-seq data with DESeq2. Genome Biol. 2014, 15, 550. [Google Scholar] [CrossRef] [PubMed]
- Syed, A.; Upton, C. Java GUI for InterProScan (JIPS): A tool to help process multiple InterProScans and perform ortholog analysis. BMC Bioinform. 2006, 7, 462. [Google Scholar] [CrossRef]
- Reich, M.; Ohm, K.; Angelo, M.; Tamayo, P.; Mesirov, J.P. GeneCluster 2.0: An advanced toolset for bioarray analysis. Bioinformatics 2004, 20, 1797–1798. [Google Scholar] [CrossRef]
- Li, Y.; Zhang, X.-T.; Piao, J.-Z.; Zhuo, R.-J.; Li, Z.-B.; Guan, H.-W. Cloning and Bioinformatics Analysis of Blue-light Receptor EaWC 1 Gene in Elsinoë arachidis. Biotechnol. Bull. 2022, 38, 93–99. [Google Scholar] [CrossRef]
- Daub, M.E.; Herrero, S.; Chung, K.-R. Photoactivated perylenequinone toxins in fungal pathogenesis of plants. FEMS Microbiol. Lett. 2005, 252, 197–206. [Google Scholar] [CrossRef]
- Schumacher, J. How light affects the life of Botrytis. Fungal Genet. Biol. 2017, 106, 26–41. [Google Scholar] [CrossRef]
- Qiu, Z.; Gao, Y.; Wang, S.; Wang, J.; Wang, X.; Cai, N.; Zhao, J.; Li, T.; Li, H.; Li, T.; et al. Mechanism Underlying Light Intensity-Induced Melanin Synthesis of Auricularia heimuer Revealed by Transcriptome Analysis. Cells 2022, 12, 56. [Google Scholar] [CrossRef]
- McCorison, C.B.; Goodwin, S.B. The wheat pathogen Zymoseptoria tritici senses and responds to different wavelengths of light. BMC Genom. 2020, 21, 513. [Google Scholar] [CrossRef]
- Yu, Z.; Fischer, R. Light sensing and responses in fungi. Nat. Rev. Microbiol. 2019, 17, 25–36. [Google Scholar] [CrossRef]
- Fuller, K.K.; Loros, J.J.; Dunlap, J.C. Fungal photobiology: Visible light as a signal for stress, space and time. Curr. Genet. 2015, 61, 275–288. [Google Scholar] [CrossRef]
- Corrochano, L.M. Light in the Fungal World: From Photoreception to Gene Transcription and Beyond. Annu. Rev. Genet. 2019, 53, 149–170. [Google Scholar] [CrossRef]
- Pardo-Medina, J.; Limon, M.C.; Avalos, J. Fusarium Photoreceptors. J. Fungi 2023, 9, 319. [Google Scholar] [CrossRef]
- Sancar, C.; Ha, N.; Yilmaz, R.; Tesorero, R.; Fisher, T.; Brunner, M.; Sancar, G. Combinatorial control of light induced chromatin remodeling and gene activation in Neurospora. PLoS Genet. 2015, 11, e1005105. [Google Scholar] [CrossRef]
- Belozerskaya, T.A.; Gessler, N.N.; Isakova, E.P.; Deryabina, Y.I. Neurospora crassa Light Signal Transduction Is Affected by ROS. J. Signal Transduct. 2012, 2012, 791963. [Google Scholar] [CrossRef]
- Castrillo, M.; Avalos, J. Light-mediated participation of the VIVID-like protein of Fusarium fujikuroi VvdA in pigmentation and development. Fungal Genet. Biol. 2014, 71, 9–20. [Google Scholar] [CrossRef] [PubMed]
- Saha, D.; Fetzner, R.; Burkhardt, B.; Podlech, J.; Metzler, M.; Dang, H.; Lawrence, C.; Fischer, R. Identification of a polyketide synthase required for alternariol (AOH) and alternariol-9-methyl ether (AME) formation in Alternaria alternata. PLoS ONE 2012, 7, e40564. [Google Scholar] [CrossRef]
- Linden, H.; Ballario, P.; Macino, G. Blue Light Regulation in Neurospora crassa. Fungal Genet. Biol. 1997, 22, 141–150. [Google Scholar] [CrossRef]
- Schwerdtfeger, C.; Linden, H. Localization and light-dependent phosphorylation of white collar 1 and 2, the two central components of blue light signaling in Neurospora crassa. Eur. J. Biochem. 2000, 267, 414–422. [Google Scholar] [CrossRef]
- Zhang, H.; Wang, G.; Yang, Q.; Yang, X.; Zheng, Y.; Liu, Y.; Xing, F. Effects of Light on the Ochratoxigenic Fungi Aspergillus ochraceus and A. carbonarius. Toxins 2021, 13, 251. [Google Scholar] [CrossRef]
- Calvo, A.M. The VeA regulatory system and its role in morphological and chemical development in fungi. Fungal Genet. Biol. 2008, 45, 1053–1061. [Google Scholar] [CrossRef]
- Sarikaya-Bayram, O.; Palmer, J.M.; Keller, N.; Braus, G.H.; Bayram, O. One Juliet and four Romeos: VeA and its methyltransferases. Front. Microbiol. 2015, 6, 1. [Google Scholar] [CrossRef]
- Ruger-Herreros, C.; Rodriguez-Romero, J.; Fernandez-Barranco, R.; Olmedo, M.; Fischer, R.; Corrochano, L.M.; Canovas, D. Regulation of conidiation by light in Aspergillus nidulans. Genetics 2011, 188, 809–822. [Google Scholar] [CrossRef]
- Wang, W.; Wu, D.; Pan, H.; Turgeon, B.G. Vel2 and Vos1 hold essential roles in ascospore and asexual spore development of the heterothallic maize pathogen Cochliobolus heterostrophus. Fungal Genet. Biol. 2014, 70, 113–124. [Google Scholar] [CrossRef]

| Sample | Raw Reads | Clean Reads | Mapped Ratio (Base)/% | Q30/% | GC Content/% |
|---|---|---|---|---|---|
| D01 | 45,669,778 | 22,834,889 | 95.97% | 94.41% | 54.79% |
| D02 | 46,787,346 | 23,393,673 | 95.47% | 94.02% | 54.67% |
| D03 | 41,349,942 | 20,674,971 | 95.56% | 94.19% | 54.85% |
| W01 | 68,671,660 | 34,335,830 | 95.71% | 94.19% | 54.84% |
| W02 | 52,122,102 | 26,061,051 | 95.80% | 94.40% | 54.88% |
| W03 | 54,285,172 | 27,142,586 | 95.85% | 94.31% | 54.90% |
Disclaimer/Publisher’s Note: The statements, opinions and data contained in all publications are solely those of the individual author(s) and contributor(s) and not of MDPI and/or the editor(s). MDPI and/or the editor(s) disclaim responsibility for any injury to people or property resulting from any ideas, methods, instructions or products referred to in the content. |
© 2024 by the authors. Licensee MDPI, Basel, Switzerland. This article is an open access article distributed under the terms and conditions of the Creative Commons Attribution (CC BY) license (https://creativecommons.org/licenses/by/4.0/).
Share and Cite
Liu, D.; Piao, J.; Li, Y.; Guan, H.; Hao, J.; Zhou, R. Transcriptome Analysis Reveals Candidate Genes for Light Regulation of Elsinochrome Biosynthesis in Elsinoë arachidis. Microorganisms 2024, 12, 1027. https://doi.org/10.3390/microorganisms12051027
Liu D, Piao J, Li Y, Guan H, Hao J, Zhou R. Transcriptome Analysis Reveals Candidate Genes for Light Regulation of Elsinochrome Biosynthesis in Elsinoë arachidis. Microorganisms. 2024; 12(5):1027. https://doi.org/10.3390/microorganisms12051027
Chicago/Turabian StyleLiu, Dan, Jingzi Piao, Yang Li, Haiwen Guan, Jingwen Hao, and Rujun Zhou. 2024. "Transcriptome Analysis Reveals Candidate Genes for Light Regulation of Elsinochrome Biosynthesis in Elsinoë arachidis" Microorganisms 12, no. 5: 1027. https://doi.org/10.3390/microorganisms12051027
APA StyleLiu, D., Piao, J., Li, Y., Guan, H., Hao, J., & Zhou, R. (2024). Transcriptome Analysis Reveals Candidate Genes for Light Regulation of Elsinochrome Biosynthesis in Elsinoë arachidis. Microorganisms, 12(5), 1027. https://doi.org/10.3390/microorganisms12051027
